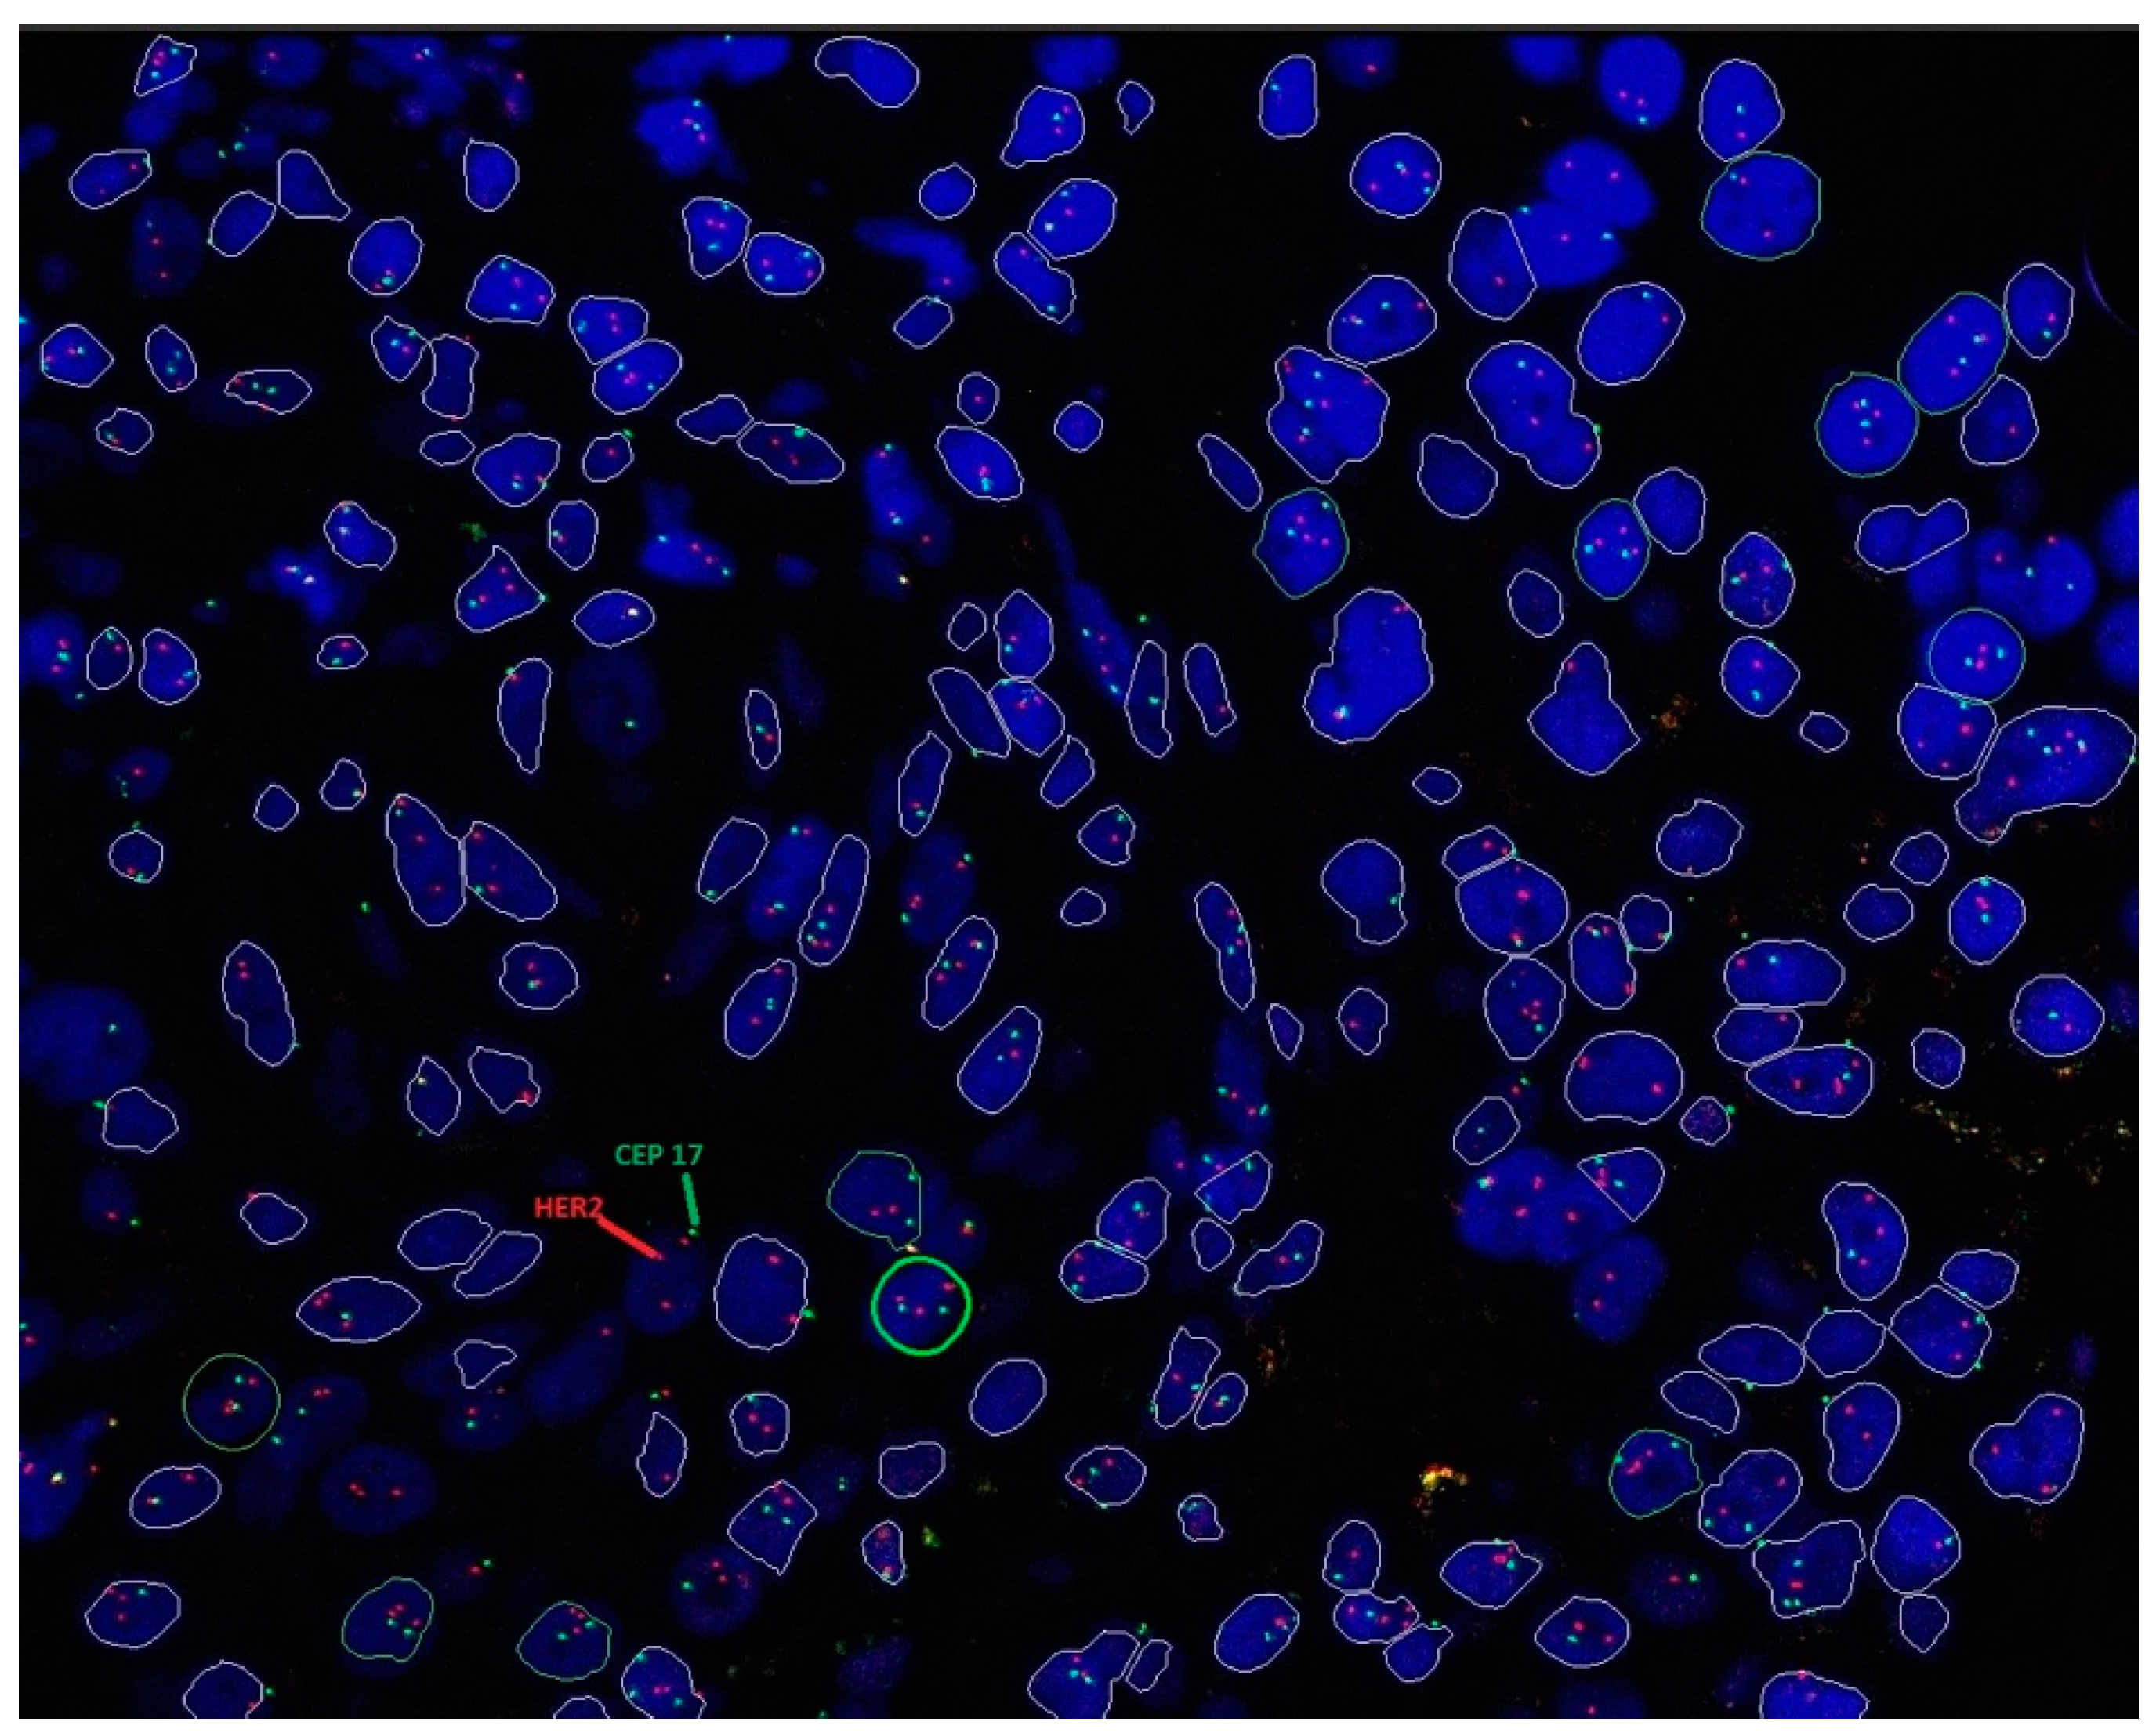
Cancers 16 02325 g002 Cancers 16 02325 g002

Consensus Guidelines on Human Epidermal Growth Factor Receptor 2 (HER2)-Low Testing in Breast Cancer in Malaysia
Abstract
Simple Summary
Abstract
1. Introduction
Current Treatment Options for HER2-Low Breast Cancer
2. Methods
3. Results
3.1. Discussion 1: Establishing HER2 Testing for Breast Cancer in Malaysia
3.2. Discussion 2: Tissue Handling and Sample Preparation
3.3. Discussion 3: Assay and Antibody Selection for HER2 Testing for Breast Cancer
3.3.1. Detection of HER2 Protein Expression
3.3.2. Detection of HER2 Gene Amplification
3.4. Discussion 4: Results’ Interpretation
3.4.1. HER2 IHC Scoring
3.4.2. HER2 ISH Testing
3.4.3. Potential Challenges in Results’ Interpretation
3.4.4. Recommended Practice in Results’ Interpretation
3.5. Discussion 5: Results Reporting
3.5.1. Reporting HER2 IHC Score
3.5.2. Reporting HER2 ISH Result
3.5.3. Reporting Heterogenous Tumors
3.6. Discussion 6: Overcoming Obstacles in HER2 Testing
3.7. Discussion 7: Upholding Quality in HER2 Testing
4. Conclusions
Author Contributions
Funding
Institutional Review Board Statement
Informed Consent Statement
Data Availability Statement
Acknowledgments
Conflicts of Interest
Disclaimer
References
- Arnold, M.; Morgan, E.; Rumgay, H.; Mafra, A.; Singh, D.; Laversanne, M.; Vignat, J.; Gralow, J.R.; Cardoso, F.; Siesling, S.; et al. Current and future burden of breast cancer: Global statistics for 2020 and 2040. Breast 2022, 66, 15–23. [Google Scholar] [CrossRef] [PubMed]
- Malaysia National Cancer Registry. Summary of Malaysia National Cancer 2012–2016. Available online: https://www.moh.gov.my/moh/resources/Penerbitan/Laporan/Umum/2012-2016%20(MNCRR)/Summary_MNCR_2012-2016_-_06112020.pdf (accessed on 12 May 2024).
- Ministry of Health Malaysia. Malaysian Study on Cancer Survival. Available online: https://www.moh.gov.my/moh/resources/Penerbitan/Laporan/Umum/Malaysian_Study_on_Cancer_Survival_MySCan_2018.pdf (accessed on 12 May 2024).
- Gutierrez, C.; Schiff, R. HER2: Biology, detection, and clinical implications. Arch. Pathol. Lab. Med. 2011, 135, 55–62. [Google Scholar] [CrossRef] [PubMed]
- Wolff, A.C.; Hammond, M.E.H.; Allison, K.H.; Harvey, B.E.; Mangu, P.B.; Bartlett, J.M.S.; Bilous, M.; Ellis, I.O.; Fitzgibbons, P.; Hanna, W.; et al. Human epidermal growth factor receptor 2 testing in breast cancer: American Society of Clinical Oncology/College of American Pathologists clinical practice guideline focused update. J. Clin. Oncol. 2018, 36, 2105–2122. [Google Scholar] [CrossRef] [PubMed]
- Subramaniam, S.; Bhoo-Pathy, N.; Taib, N.A.; Tan, G.H.; See, M.H.; Jamaris, S.; Ho, G.F.; Looi, L.M.; Yip, C.H. Breast cancer outcomes as defined by the estrogen receptor, progesterone receptor, and human growth factor receptor-2 in a multi-ethnic Asian country. World J. Surg. 2015, 39, 2450–2458. [Google Scholar] [CrossRef] [PubMed]
- Devi, C.R.; Tang, T.S.; Corbex, M. Incidence and risk factors for breast cancer subtypes in three distinct South-East Asian ethnic groups: Chinese, Malay and natives of Sarawak, Malaysia. Int. J. Cancer 2012, 131, 2869–2877. [Google Scholar] [CrossRef] [PubMed]
- Pan, J.-W.; Zabidi, M.M.A.; Ng, P.-S.; Meng, M.-Y.; Hasan, S.N.; Sandey, B.; Sammut, S.-J.; Yip, C.-H.; Rajadurai, P.; Rueda, O.M.; et al. The molecular landscape of Asian breast cancers reveals clinically relevant population-specific differences. Nat. Commun. 2020, 11, 6433. [Google Scholar] [CrossRef] [PubMed]
- Howlader, N.; Cronin, K.A.; Kurian, A.W.; Andridge, R. Differences in breast cancer survival by molecular subtypes in the United States. Cancer Epidemiol. Biomark. Prev. 2018, 27, 619–626. [Google Scholar] [CrossRef]
- Moja, L.; Tagliabue, L.; Balduzzi, S.; Parmelli, E.; Pistotti, V.; Guarneri, V.; D’Amico, R. Trastuzumab containing regimens for early breast cancer. Cochrane Database Syst. Rev. 2012, 2012, Cd006243. [Google Scholar] [CrossRef]
- Ishii, K.; Morii, N.; Yamashiro, H. Pertuzumab in the treatment of HER2-positive breast cancer: An evidence-based review of its safety, efficacy, and place in therapy. Core Evid. 2019, 14, 51–70. [Google Scholar] [CrossRef]
- Geyer, C.E.; Forster, J.; Lindquist, D.; Chan, S.; Romieu, C.G.; Pienkowski, T.; Jagiello-Gruszfeld, A.; Crown, J.; Chan, A.; Kaufman, B.; et al. Lapatinib plus capecitabine for HER2-positive advanced breast cancer. N. Engl. J. Med. 2006, 355, 2733–2743. [Google Scholar] [CrossRef]
- Krop, I.E.; Kim, S.B.; Martin, A.G.; LoRusso, P.M.; Ferrero, J.M.; Badovinac-Crnjevic, T.; Hoersch, S.; Smitt, M.; Wildiers, H. Trastuzumab emtansine versus treatment of physician’s choice in patients with previously treated HER2-positive metastatic breast cancer (TH3RESA): Final overall survival results from a randomised open-label phase 3 trial. Lancet Oncol. 2017, 18, 743–754. [Google Scholar] [CrossRef] [PubMed]
- Schettini, F.; Chic, N.; Brasó-Maristany, F.; Paré, L.; Pascual, T.; Conte, B.; Martínez-Sáez, O.; Adamo, B.; Vidal, M.; Barnadas, E.; et al. Clinical, pathological, and PAM50 gene expression features of HER2-low breast cancer. NPJ Breast Cancer 2021, 7, 1. [Google Scholar] [CrossRef] [PubMed]
- Tarantino, P.; Hamilton, E.; Tolaney, S.M.; Cortes, J.; Morganti, S.; Ferraro, E.; Marra, A.; Viale, G.; Trapani, D.; Cardoso, F.; et al. HER2-low breast cancer: Pathological and clinical landscape. J. Clin. Oncol. 2020, 38, 1951–1962. [Google Scholar] [CrossRef] [PubMed]
- Modi, S.; Jacot, W.; Yamashita, T.; Sohn, J.; Vidal, M.; Tokunaga, E.; Tsurutani, J.; Ueno, N.T.; Prat, A.; Chae, Y.S.; et al. Trastuzumab deruxtecan in previously treated HER2-low advanced breast cancer. N. Engl. J. Med. 2022, 387, 9–20. [Google Scholar] [CrossRef] [PubMed]
- The ASCO Post. FDA Approves First Targeted Therapy for HER2-Low Breast Cancer. Available online: https://ascopost.com/issues/september-10-2022/fda-approves-first-targeted-therapy-for-her2-low-breast-cancer/ (accessed on 12 May 2024).
- Sakach, E.; Sacks, R.; Kalinsky, K. Trop-2 as a therapeutic target in breast cancer. Cancers 2022, 14, 5936. [Google Scholar] [CrossRef] [PubMed]
- United States Food and Drug Administration. FDA Grants Regular Approval to Sacituzumab Govitecan for Triple-Negative Breast Cancer. Available online: https://www.fda.gov/drugs/resources-information-approved-drugs/fda-grants-regular-approval-sacituzumab-govitecan-triple-negative-breast-cancer (accessed on 12 May 2024).
- United States Food and Drug Administration. FDA Approves Sacituzumab Govitecan-Hziy for HR-Positive Breast Cancer. Available online: https://www.fda.gov/drugs/resources-information-approved-drugs/fda-approves-sacituzumab-govitecan-hziy-hr-positive-breast-cancer (accessed on 12 May 2024).
- United States Food and Drug Administration. TRODELVY® (Sacituzumab Govitecan-Hziy) for Injection, for Intravenous Use. Available online: https://www.accessdata.fda.gov/drugsatfda_docs/label/2023/761115s035lbl.pdf (accessed on 12 May 2024).
- Rugo, H.S.; Bardia, A.; Marmé, F.; Cortés, J.; Schmid, P.; Loirat, D.; Tredan, O.; Ciruelos, E.M.; Dalenc, F.; Gomez Pardo, P.; et al. LBA76 overall survival (OS) results from the phase III TROPiCS-02 study of sacituzumab govitecan (SG) vs treatment of physician’s choice (TPC) in patients (pts) with HR+/HER2- metastatic breast cancer (mBC). Ann. Oncol. 2022, 33, S1386. [Google Scholar] [CrossRef]
- ClinicalTrials.gov. Study of DS-8201a, an Antibody Drug Conjugate for Advanced Breast Cancer Patients, with Biomarkers Analysis (DAISY). Available online: https://clinicaltrials.gov/ct2/show/NCT04132960 (accessed on 12 May 2024).
- Diéras, V.; Deluche, E.; Lusque, A.; Pistilli, B.; Bachelot, T.; Pierga, J.-Y.; Viret, F.; Levy, C.; Salabert, L.; Du, F.L.; et al. Abstract PD8-02: Trastuzumab deruxtecan (T-DXd) for advanced breast cancer patients (ABC), regardless HER2 status: A phase II study with biomarkers analysis (DAISY). Cancer Res. 2022, 82, PD8-02. [Google Scholar] [CrossRef]
- ClinicalTrials.gov. Study of Trastuzumab Deruxtecan (T-DXd) vs. Investigator’s Choice Chemotherapy in HER2-Low, Hormone Receptor Positive, Metastatic Breast Cancer (DB-06). Available online: https://clinicaltrials.gov/ct2/show/NCT04494425 (accessed on 12 May 2024).
- ClinicalTrials.gov. A Phase 1b Study of T-DXd Combinations in HER2-Low Advanced or Metastatic Breast Cancer (DB-08). Available online: https://clinicaltrials.gov/ct2/show/NCT04556773 (accessed on 12 May 2024).
- ClinicalTrials.gov. Phase 2 Study of the Monoclonal Antibody MGAH22 (Margetuximab) in Patients with Relapsed or Refractory Advanced Breast Cancer. Available online: https://clinicaltrials.gov/ct2/show/NCT01828021 (accessed on 12 May 2024).
- Banerji, U.; van Herpen, C.M.L.; Saura, C.; Thistlethwaite, F.; Lord, S.; Moreno, V.; Macpherson, I.R.; Boni, V.; Rolfo, C.; de Vries, E.G.E.; et al. Trastuzumab duocarmazine in locally advanced and metastatic solid tumours and HER2-expressing breast cancer: A phase 1 dose-escalation and dose-expansion study. Lancet Oncol. 2019, 20, 1124–1135. [Google Scholar] [CrossRef]
- Wang, J.; Liu, Y.; Zhang, Q.; Feng, J.; Fang, J.; Chen, X.; Han, Y.; Li, Q.; Zhang, P.; Yuan, P.; et al. RC48-ADC, a HER2-targeting antibody-drug conjugate, in patients with HER2-positive and HER2-low expressing advanced or metastatic breast cancer: A pooled analysis of two studies. J. Clin. Oncol. 2021, 39, 1022. [Google Scholar] [CrossRef]
- Li, J.; Guo, Y.; Xue, J.L.; Peng, W.; Ge, X.X.; Zhao, W.; Dai, C.Q.; Xue, L.Q.; Tang, W.B.; Hu, C.H. First-in-human phase I study of anti-HER2 ADC MRG002 in patients with relapsed/refractory solid tumors. J. Clin. Oncol. 2020, 38, TPS1101. [Google Scholar] [CrossRef]
- Wolff, A.C.; Somerfield, M.R.; Dowsett, M.; Hammond, M.E.H.; Hayes, D.F.; McShane, L.M.; Saphner, T.J.; Spears, P.A.; Allison, K.H. Human epidermal growth factor receptor 2 testing in breast cancer: ASCO–College of American Pathologists guideline update. J. Clin. Oncol. 2023, 41, 3867–3872. [Google Scholar] [CrossRef] [PubMed]
- Md Pauzi, S.H.; Masir, N.; Yahaya, A.; Mohammed, F.; Tizen Laim, N.M.S.; Mustangin, M.; Aizudin, A.N.; Talib, A.; Teoh, K.H.; Karim, N.; et al. HER2 testing by immunohistochemistry in breast cancer: A multicenter proficiency ring study. Indian J. Pathol. Microbiol. 2021, 64, 677–682. [Google Scholar] [CrossRef] [PubMed]
- Ministry of Health Malaysia. HER2 Testing. Available online: https://www.moh.gov.my/index.php/database_stores/attach_download/347/115 (accessed on 12 May 2024).
- Wolff, A.C.; Hammond, M.E.H.; Hicks, D.G.; Dowsett, M.; McShane, L.M.; Allison, K.H.; Allred, D.C.; Bartlett, J.M.S.; Bilous, M.; Fitzgibbons, P.; et al. Recommendations for human epidermal growth factor receptor 2 testing in breast cancer: American Society of Clinical Oncology/College of American Pathologists clinical practice guideline update. Arch. Pathol. Lab. Med. 2013, 138, 241–256. [Google Scholar] [CrossRef] [PubMed]
- Mitra, S.; Dey, P. Fine-needle aspiration and core biopsy in the diagnosis of breast lesions: A comparison and review of the literature. Cytojournal 2016, 13, 18. [Google Scholar] [CrossRef] [PubMed]
- Li, H.N.; Chen, C.H. Ultrasound-guided core needle biopsies of breast invasive carcinoma: When one core is sufficient for pathologic diagnosis and assessment of hormone receptor and HER2 status. Diagnostics 2019, 9, 54. [Google Scholar] [CrossRef] [PubMed]
- Kim, S.W.; Roh, J.; Park, C.S. Immunohistochemistry for pathologists: Protocols, pitfalls, and tips. J. Pathol. Transl. Med. 2016, 50, 411–418. [Google Scholar] [CrossRef] [PubMed]
- Wolff, A.C.; Hammond, M.E.H.; Schwartz, J.N.; Hagerty, K.L.; Allred, D.C.; Cote, R.J.; Dowsett, M.; Fitzgibbons, P.L.; Hanna, W.M.; Langer, A.; et al. American Society of Clinical Oncology/College of American Pathologists guideline recommendations for human epidermal growth factor receptor 2 testing in breast cancer. Arch. Pathol. Lab. Med. 2007, 131, 18–43. [Google Scholar] [CrossRef]
- Li, X.; Deavers, M.T.; Guo, M.; Liu, P.; Gong, Y.; Albarracin, C.T.; Middleton, L.P.; Huo, L. The effect of prolonged cold ischemia time on estrogen receptor immunohistochemistry in breast cancer. Mod. Pathol. 2013, 26, 71–78. [Google Scholar] [CrossRef]
- Bass, B.P.; Engel, K.B.; Greytak, S.R.; Moore, H.M. A review of preanalytical factors affecting molecular, protein, and morphological analysis of formalin-fixed, paraffin-embedded (FFPE) tissue: How well do you know your FFPE specimen? Arch. Pathol. Lab. Med. 2014, 138, 1520–1530. [Google Scholar] [CrossRef]
- Wong, Y.P.; Abu Backer, F.M.; Tan, G.C.; Looi, L.M.; Mat Salleh, M.J.; A Subramaniam, P.A.; Rahimi, R.; Ariffin, R.; Razali, R.H.; Siew, S.F.; et al. Guidelines on retention of pathology records and materials (Version 2/2022). Malays. J. Pathol. 2022, 44, 165–176. [Google Scholar]
- Rakha, E.A.; Pinder, S.E.; Bartlett, J.M.S.; Ibrahim, M.; Starczynski, J.; Carder, P.J.; Provenzano, E.; Hanby, A.; Hales, S.; Lee, A.H.S.; et al. Updated UK Recommendations for HER2 assessment in breast cancer. J. Clin. Pathol. 2015, 68, 93. [Google Scholar] [CrossRef] [PubMed]
- Yamashita-Kashima, Y.; Shu, S.; Yorozu, K.; Hashizume, K.; Moriya, Y.; Fujimoto-Ouchi, K.; Harada, N. Importance of formalin fixing conditions for HER2 testing in gastric cancer: Immunohistochemical staining and fluorescence in situ hybridization. Gastric Cancer 2014, 17, 638–647. [Google Scholar] [CrossRef]
- Ramos-Vara, J.A.; Webster, J.D.; DuSold, D.; Miller, M.A. Immunohistochemical evaluation of the effects of paraffin section storage on biomarker stability. Vet. Pathol. 2014, 51, 102–109. [Google Scholar] [CrossRef] [PubMed]
- Zhang, H.; Moisini, I.; Ajabnoor, R.M.; Turner, B.M.; Hicks, D.G. Applying the new guidelines of HER2 testing in breast cancer. Curr. Oncol. Rep. 2020, 22, 51. [Google Scholar] [CrossRef]
- Rosa, F.E.; Santos, R.M.; Rogatto, S.R.; Domingues, M.A. Chromogenic in situ hybridization compared with other approaches to evaluate HER2/neu status in breast carcinomas. Braz. J. Med. Biol. Res. 2013, 46, 207–216. [Google Scholar] [CrossRef]
- The Pew Charitable Trusts. The Role of Lab-Developed Tests in the In Vitro Diagnostics Market. Available online: https://www.pewtrusts.org/-/media/assets/2021/10/understanding-the-role-of-lab-developed-tests-in-vitro-diagnostics.pdf (accessed on 12 May 2024).
- Congressional Research Service. Regulation of Clinical Tests: In Vitro Diagnostic (IVD) Devices, Laboratory Developed Tests (LDTs), and Genetic Tests. Available online: https://sgp.fas.org/crs/misc/R43438.pdf (accessed on 12 May 2024).
- United States Food and Drug Administration. Premarket Approval (PMA)—PATHWAY Anti-HER-2/neu (4B5) Rabbit Monoclonal Primary Antibody. Available online: https://www.accessdata.fda.gov/scripts/cdrh/cfdocs/cfpma/pma.cfm?id=P990081S047 (accessed on 23 May 2024).
- United States Food and Drug Administration. Premarket Approval (PMA)—Dako HercepTest. Available online: https://www.accessdata.fda.gov/scripts/cdrh/cfdocs/cfpma/pma.cfm?id=P980018 (accessed on 23 May 2024).
- United States Food and Drug Administration. Premarket Approval (PMA)—Bond Oracle HER2 IHC System. Available online: https://www.accessdata.fda.gov/scripts/cdrh/cfdocs/cfpma/pma.cfm?id=P090015 (accessed on 23 May 2024).
- United States Food and Drug Administration. Premarket Approval (PMA)—InSite Her-2/neu kit. Available online: https://www.accessdata.fda.gov/scripts/cdrh/cfdocs/cfpma/pma.cfm?id=p040030 (accessed on 23 May 2024).
- Furrer, D.; Sanschagrin, F.; Jacob, S.; Diorio, C. Advantages and disadvantages of technologies for HER2 testing in breast cancer specimens. Am. J. Clin. Pathol. 2015, 144, 686–703. [Google Scholar] [CrossRef]
- United States Food and Drug Administration. PATHWAY Anti-HER-2/Neu (4B5) Rabbit Monoclonal Primary Antibody—P990081/S047. Available online: https://www.fda.gov/medical-devices/recently-approved-devices/pathway-anti-her-2neu-4b5-rabbit-monoclonal-primary-antibody-p990081s047 (accessed on 12 May 2024).
- Tarantino, P.; Viale, G.; Press, M.F.; Hu, X.; Penault-Llorca, F.; Bardia, A.; Batistatou, A.; Burstein, H.J.; Carey, L.A.; Cortes, J.; et al. ESMO expert consensus statements (ECS) on the definition, diagnosis, and management of HER2-low breast cancer. Ann. Oncol. 2023, 34, 645–659. [Google Scholar] [CrossRef]
- Scott, M.; Vandenberghe, M.E.; Scorer, P.; Boothman, A.-M.; Barker, C. Prevalence of HER2 low in breast cancer subtypes using the VENTANA anti-HER2/neu (4B5) assay. J. Clin. Oncol. 2021, 39, 1021. [Google Scholar] [CrossRef]
- Rüschoff, J.; Friedrich, M.; Nagelmeier, I.; Kirchner, M.; Andresen, L.M.; Salomon, K.; Portier, B.; Sredni, S.T.; Schildhaus, H.U.; Jasani, B.; et al. Comparison of HercepTest™ mAb pharmDx (Dako Omnis, GE001) with Ventana PATHWAY anti-HER-2/neu (4B5) in breast cancer: Correlation with HER2 amplification and HER2 low status. Virchows Arch. 2022, 481, 685–694. [Google Scholar] [CrossRef]
- Nicolò, E.; Boscolo Bielo, L.; Curigliano, G.; Tarantino, P. The HER2-low revolution in breast oncology: Steps forward and emerging challenges. Ther. Adv. Med. Oncol. 2023, 15, 17588359231152842. [Google Scholar] [CrossRef]
- United States Food and Drug Administration. Premarket Approval (PMA)—SPOT-LIGHT HER2 CISH KIT. Available online: https://www.accessdata.fda.gov/scripts/cdrh/cfdocs/cfpma/pma.cfm?id=p050040 (accessed on 23 May 2024).
- Dako. HER2 CISH pharmDxTm Kit. Available online: https://www.accessdata.fda.gov/cdrh_docs/pdf10/P100024c.pdf (accessed on 12 May 2024).
- Vysis Inc. PathVysion HER-2 DNA Probe Kit. Available online: https://www.accessdata.fda.gov/cdrh_docs/pdf/P980024S001c.pdf (accessed on 12 May 2024).
- United States Food and Drug Administration. Premarket Approval (PMA)—DakoCytomation HER2 FISH pharmDx Kit. Available online: https://www.accessdata.fda.gov/scripts/cdrh/cfdocs/cfpma/pma.cfm?id=P040005 (accessed on 23 May 2024).
- United States Food and Drug Administration. Premarket Approval (PMA)—VENTANA HER2 Dual ISH DNA Probe Cocktail. Available online: https://www.accessdata.fda.gov/scripts/cdrh/cfdocs/cfpma/pma.cfm?id=P190031S007 (accessed on 23 May 2024).
- Olsson, H.; Jansson, A.; Holmlund, B.; Gunnarsson, C. Methods for evaluating HER2 status in breast cancer: Comparison of IHC, FISH, and real-time PCR analysis of formalin-fixed paraffin-embedded tissue. Pathol. Lab. Med. Int. 2013, 5, 31–37. [Google Scholar] [CrossRef][Green Version]
- Tvrdík, D.; Staněk, L.; Skálová, H.; Dundr, P.; Velenská, Z.; Povýšil, C. Comparison of the IHC, FISH, SISH and qPCR methods for the molecular diagnosis of breast cancer. Mol. Med. Rep. 2012, 6, 439–443. [Google Scholar] [CrossRef] [PubMed][Green Version]
- Ahn, S.; Woo, J.W.; Lee, K.; Park, S.Y. HER2 status in breast cancer: Changes in guidelines and complicating factors for interpretation. J. Pathol. Transl. Med. 2020, 54, 34–44. [Google Scholar] [CrossRef] [PubMed]
- Hou, Y.; Nitta, H.; Li, Z. HER2 intratumoral heterogeneity in breast cancer, an evolving concept. Cancers 2023, 15, 2664. [Google Scholar] [CrossRef] [PubMed]
- Ohlschlegel, C.; Zahel, K.; Kradolfer, D.; Hell, M.; Jochum, W. HER2 genetic heterogeneity in breast carcinoma. J. Clin. Pathol. 2011, 64, 1112–1116. [Google Scholar] [CrossRef] [PubMed]
- Vance, G.H.; Barry, T.S.; Bloom, K.J.; Fitzgibbons, P.L.; Hicks, D.G.; Jenkins, R.B.; Persons, D.L.; Tubbs, R.R.; Hammond, M.E. Genetic heterogeneity in HER2 testing in breast cancer: Panel summary and guidelines. Arch. Pathol. Lab. Med. 2009, 133, 611–612. [Google Scholar] [CrossRef] [PubMed]
- Liwski, C.R.; Castonguay, M.C.; Barnes, P.J.; Rayson, D.; Bethune, G.C. HER2 testing in metastatic breast cancer—Is reflex ISH testing necessary on HER2 IHC-equivocal (2+) cases? Ann. Diagn. Pathol. 2022, 59, 151953. [Google Scholar] [CrossRef]
- Scheel, A.H.; Penault-Llorca, F.; Hanna, W.; Baretton, G.; Middel, P.; Burchhardt, J.; Hofmann, M.; Jasani, B.; Rüschoff, J. Physical basis of the ‘magnification rule’ for standardized Immunohistochemical scoring of HER2 in breast and gastric cancer. Diagn. Pathol. 2018, 13, 19. [Google Scholar] [CrossRef]
- Koopman, T.; Buikema, H.J.; Hollema, H.; de Bock, G.H.; van der Vegt, B. What is the added value of digital image analysis of HER2 immunohistochemistry in breast cancer in clinical practice? A study with multiple platforms. Histopathology 2019, 74, 917–924. [Google Scholar] [CrossRef]
- Evans, A.J.; Brown, R.W.; Bui, M.M.; Chlipala, E.A.; Lacchetti, C.; Milner, D.A.; Pantanowitz, L.; Parwani, A.V.; Reid, K.; Riben, M.W.; et al. Validating whole slide imaging systems for diagnostic purposes in pathology. Arch. Pathol. Lab. Med. 2022, 146, 440–450. [Google Scholar] [CrossRef]
- College of American Pathologists. Template for Reporting Results of Biomarker Testing of Specimens from Patients with Carcinoma of the Breast. Available online: https://documents.cap.org/protocols/cp-breast-biomarker-20-1400.pdf (accessed on 12 May 2024).
- Lim, G.C.; Aina, E.N.; Cheah, S.K.; Ismail, F.; Ho, G.F.; Tho, L.M.; Yip, C.H.; Taib, N.A.; Chong, K.J.; Dharmaratnam, J.; et al. Closing the global cancer divide—performance of breast cancer care services in a middle income developing country. BMC Cancer 2014, 14, 212. [Google Scholar] [CrossRef] [PubMed]
- Lambein, K.; Van Bockstal, M.; Vandemaele, L.; Geenen, S.; Rottiers, I.; Nuyts, A.; Matthys, B.; Praet, M.; Denys, H.; Libbrecht, L. Distinguishing score 0 from score 1+ in HER2 immunohistochemistry-negative breast cancer: Clinical and pathobiological relevance. Am. J. Clin. Pathol. 2013, 140, 561–566. [Google Scholar] [CrossRef] [PubMed]

| Discussion 1: Establishing HER2 testing for breast cancer in Malaysia |
|---|
|
| Discussion 2: Tissue handling and sample preparation |
|
| Discussion 3: Assay and antibody selection for HER2 testing for breast cancer |
|
| Discussion 4: Result interpretation |
|
| Discussion 5: Results reporting |
|
| Discussion 6: Overcoming obstacles in HER2 testing |
|
| Discussion 7: Upholding quality in HER2 testing |
The following strategies may be taken to ensure quality in HER2 testing:
|
| Parameter | Recommendation |
|---|---|
| Cold ischemia time | As short as possible (one hour or less) |
| Fixative | 10% neutral buffered formalin |
| Time of fixation | 6–72 h |
| Preparation | Paraffin-embedded; sliced at 5- to 10-µm intervals |
| Use of tissue section | Should ideally be used within 1 week of slide preparation |
| Storage time for tissue sections | Sections should be stored in a closed box at 2–8 °C, and should be used within 6 weeks |
| Storage condition and time for FFPE blocks | Should be protected from light, heat, and humidity. The period of storage should comply with local regulatory requirements (20 years in Malaysia) |
| Decalcification | When decalcification is performed, EDTA should be used, and strong acids should be avoided |
| Antibody | Description | Platform |
|---|---|---|
| PATHWAY anti-HER2/neu (4B5) [49] | Rabbit monoclonal primary antibody | Ventana BenchMark ULTRA IHC/ISH System |
| HercepTest pharmDx [50] | Rabbit monoclonal primary antibody | Dako Omnis, Automated Link Platforms, Dako Autostainer or manually |
| CB11 Oracle [51] | Mouse monoclonal primary antibody | Leica Bond Oracle HER2 IHC System |
| InSite Her-2/neu (Clone CB11) [52] | Mouse monoclonal primary antibody | BioGenex i6000™ Automated Staining System and the Optimax® Plus Consolidated Staining System |
| Type of ISH | Principle of Test | Advantages | Disadvantages |
|---|---|---|---|
| CISH | Indirect labeling using chromogens |
|
|
| FISH | Fluorescent-labeled DNA probes that produces colored signals |
|
|
| SISH | Indirect labeling using DNP-labeled probes |
| - |
| DDISH | Utilizes both silver and chromogen detection systems. |
| - |
| Type of ISH | FDA-Approved Test Kit |
|---|---|
| CISH | |
| FISH | |
| DDISH |
|
| IHC Score | ASCO/CAP Guidelines Definition |
|---|---|
| 0 | No staining observed or membrane staining that is incomplete and is faint or barely perceptible and in ≤10% of the invasive tumor cells. |
| 1+ | Incomplete membrane staining that is faint or barely perceptible and in >10% of the invasive tumor cells. |
| 2+ | Invasive breast cancer with weak to moderate complete membrane staining observed in >10% of tumor cells. Test result is reported as equivocal and must undergo reflex ISH test. |
| 3+ | Circumferential membrane staining that is complete, intense and in >10% of tumor cells. |
| HER2 IHC Result | IHC Score |
|---|---|
| Negative | Score 0 (no staining observed or membrane staining that is incomplete and is faint or barely perceptible and in ≤10% of the invasive tumor cells) |
| Score 1+ * (incomplete membrane staining that is faint or barely perceptible and in >10% of the invasive tumor cells) | |
| Equivocal | Score 2+ * (invasive breast cancer with weak to moderate complete membrane staining observed in >10% of tumor cells) |
| Positive | Score 3+ (circumferential membrane staining that is complete, intense and in >10% of tumor cells) |
| HER2 ISH Status | Criteria (Dual-Probe Assay) |
|---|---|
| Positive (amplified) | HER2/CEP17 ratio ≥2.0 and average HER2 copy number ≥4.0 signals/cell (group 1) |
| HER2/CEP17 ratio ≥2.0 and average HER2 copy number <4.0 signals/cell (group 2) with concurrent IHC 3+ | |
| HER2/CEP17 ratio <2.0 and average HER2 copy number ≥6.0 signals/cell (group 3) with concurrent IHC 2+ a | |
| HER2/CEP17 ratio <2.0 and average HER2 copy number ≥6.0 signals/cell (group 3) with concurrent IHC 3+ | |
| HER2/CEP17 ratio <2.0 with average HER2 copy number ≥4.0 and <6.0 signals/cell (group 4) with concurrent IHC 3+ | |
| Negative (non-amplified) | HER2/CEP17 ratio <2.0 with average HER2 copy number <4.0 signals/cell (group 5) |
| HER2/CEP17 ratio ≥2.0 and average HER2 copy number <4.0 signals/cell (group 2) with concurrent IHC 2+ b | |
| HER2/CEP17 ratio <2.0 with average HER2 copy number ≥4.0 and <6.0 signals/cell (group 4) with concurrent IHC 2+ b | |
| Groups 2, 3, and 4 with concurrent IHC 0 or 1 + |
Disclaimer/Publisher’s Note: The statements, opinions and data contained in all publications are solely those of the individual author(s) and contributor(s) and not of MDPI and/or the editor(s). MDPI and/or the editor(s) disclaim responsibility for any injury to people or property resulting from any ideas, methods, instructions or products referred to in the content. |
© 2024 by the authors. Licensee MDPI, Basel, Switzerland. This article is an open access article distributed under the terms and conditions of the Creative Commons Attribution (CC BY) license (https://creativecommons.org/licenses/by/4.0/).
Share and Cite
Rajadurai, P.; Ravindran, S.; Lee, B.R.; Md Pauzi, S.H.; Chiew, S.F.; Teoh, K.H.; S. Raja Gopal, N.; Md Yusof, M.; Yip, C.H. Consensus Guidelines on Human Epidermal Growth Factor Receptor 2 (HER2)-Low Testing in Breast Cancer in Malaysia. Cancers 2024, 16, 2325. https://doi.org/10.3390/cancers16132325
Rajadurai P, Ravindran S, Lee BR, Md Pauzi SH, Chiew SF, Teoh KH, S. Raja Gopal N, Md Yusof M, Yip CH. Consensus Guidelines on Human Epidermal Growth Factor Receptor 2 (HER2)-Low Testing in Breast Cancer in Malaysia. Cancers. 2024; 16(13):2325. https://doi.org/10.3390/cancers16132325
Chicago/Turabian StyleRajadurai, Pathmanathan, Sarala Ravindran, Bang Rom Lee, Suria Hayati Md Pauzi, Seow Fan Chiew, Kean Hooi Teoh, Navarasi S. Raja Gopal, Mastura Md Yusof, and Cheng Har Yip. 2024. "Consensus Guidelines on Human Epidermal Growth Factor Receptor 2 (HER2)-Low Testing in Breast Cancer in Malaysia" Cancers 16, no. 13: 2325. https://doi.org/10.3390/cancers16132325
APA StyleRajadurai, P., Ravindran, S., Lee, B. R., Md Pauzi, S. H., Chiew, S. F., Teoh, K. H., S. Raja Gopal, N., Md Yusof, M., & Yip, C. H. (2024). Consensus Guidelines on Human Epidermal Growth Factor Receptor 2 (HER2)-Low Testing in Breast Cancer in Malaysia. Cancers, 16(13), 2325. https://doi.org/10.3390/cancers16132325

